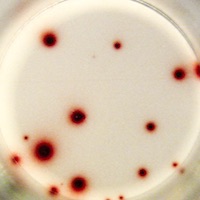

IL-21 specific spots produced by 5x10E4 human PBMCs.
Stimulation: Phytohaemagglutinin.
Stimulation: Phytohaemagglutinin.
Catalogue Number
CT419-PR2
Description
Human IL-21 T cell ELISPOT kit - 2-plate
Price
€ 465.00
staining
Enzymatic
Characteristics
PVDF
Contents
- coating antibodies
- biotinylated detection antibodies
- Streptavidin-Horseradish Peroxidase
- AEC coloring system
- Blocking stock solution
- Dilution buffer Q
- PVDF ELISPOT plates with lids and cover slips
- detailed manual
References list
- Repeated COVID-19 Vaccination Drives Memory T- and B-cell Responses in Kidney Transplant Recipients: Results From a Multicenter Randomized Controlled Trial.
- Alloreactive T cells to Assess Acute Rejection Risk in Kidney Transplant Recipients.
- The Number of Donor-Specific IL-21 Producing Cells Before and After Transplantation Predicts Kidney Graft Rejection.